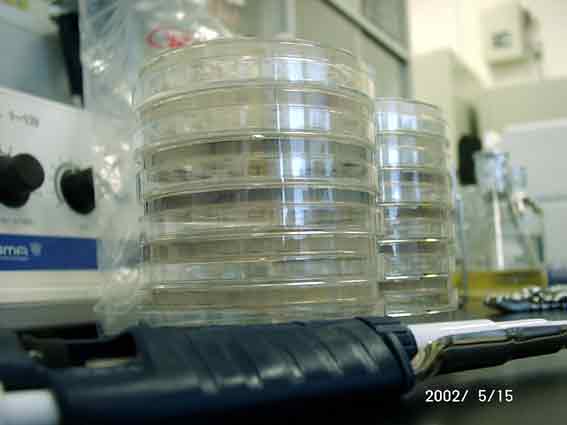

|
 |
|
卒業研究(4年生) 1期 岩崎 ゆみ (宮城県) |
|
 |
 |
|
自由研究 1年生(4期)荒川恵美(埼玉県) 1年生(4期)石清水晶子(北海道) 1年生(4期)色川詠美子(秋田県) 1年生(4期)石本友美(北海道) マウス室おそうじボランティア 4期 反町朋子 (群馬県) |
 |
 |
 |
| Back |  |
|
|
||
|
|
 |
 |
|
卒業研究(4年生) 1期 岩崎 ゆみ (宮城県) |
|
 |
 |
|
自由研究 1年生(4期)荒川恵美(埼玉県) 1年生(4期)石清水晶子(北海道) 1年生(4期)色川詠美子(秋田県) 1年生(4期)石本友美(北海道) マウス室おそうじボランティア 4期 反町朋子 (群馬県) |
 |
|
 |
| Back |  |